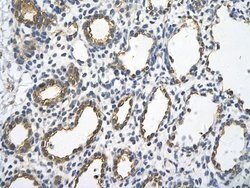
Invitrogen UBE2J1 Polyclonal Antibody 100 &mu;L | Buy Online | Invitrogen&trade; | Fisher Scientific

missing translation for 'onlineSavingsMsg'
Learn More
Learn More
Invitrogen™ UBE2J1 Polyclonal Antibody


Description
Peptide sequence: METRYNLKSP AVKRLMKEAA ELKDPTDHYH AQPLEDNLFE WHFTVRGPPD Sequence homology: Guinea Pig: 100%; Human: 100%; Mouse: 100%; Rabbit: 100%; Rat: 100%; Zebrafish: 86%.
The modification of proteins with ubiquitin is an important cellular mechanism for targeting abnormal or short-lived proteins for degradation. Ubiquitination involves at least three classes of enzymes: ubiquitin-activating enzymes, or E1s, ubiquitin-conjugating enzymes, or E2s, and ubiquitin-protein ligases, or E3s. This gene encodes a member of the E2 ubiquitin-conjugating enzyme family. This enzyme is located in the membrane of the endoplasmic reticulum and may contribute to quality control ER-associated degradation by the ubiquitin-proteasome system.

Specifications
Specifications
| Antigen | UBE2J1 |
| Applications | Immunohistochemistry (Paraffin), Western Blot |
| Classification | Polyclonal |
| Concentration | 1 mg/mL |
| Conjugate | Unconjugated |
| Formulation | PBS with 2% sucrose and 0.09% sodium azide |
| Gene | Ube2j1 |
| Gene Accession No. | Q9Y385 |
| Gene Alias | 0710008M05Rik; 1110030I22Rik; CGI-76; E2 ubiquitin-conjugating enzyme J1; HSPC153; HSPC205; HSU93243; HsUBC6e; MGC12555; Ncube; NCUBE1; NCUBE-1; non-canonical ubiquitin conjugating enzyme 1; non-canonical ubiquitin-conjugating enzyme 1; UBC6; UBC6E; Ubc6p; Ube2j1; ubiquitin conjugating enzyme E2 J1; ubiquitin conjugating enzyme E2, J1; ubiquitin-conjugating enzyme E2 J1; ubiquitin-conjugating enzyme E2, J1; ubiquitin-conjugating enzyme E2, J1 (UBC6 homolog, yeast); ubiquitin-conjugating enzyme E2, J1, U; ubiquitin-conjugating enzyme E2J 1; yeast ubiquitin-conjugating enzyme UBC6 homolog E; zgc:63554 |
| Gene Symbols | Ube2j1 |
| Show More |
Product Title
By clicking Submit, you acknowledge that you may be contacted by Fisher Scientific in regards to the feedback you have provided in this form. We will not share your information for any other purposes. All contact information provided shall also be maintained in accordance with our Privacy Policy.
Spot an opportunity for improvement?